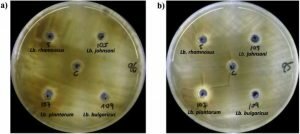

Scientific Papers
MycoKey aims to unlock new knowledge and to valorize existing knowledge and data by rapid dissemination to research partners and stakeholders in the chain.
In the MycoKey programme all scientific peer reviewed publications are available through open access. Research data will be deposited in public data repositories for (re)-analysis exploitation and dissemination free of charge.
In this page you can find publications describing the scientific results arising from project’s activities.
Fusarium species are among the most important fungal pathogens of maize, where they cause severe reduction of yield and accumulation of a wide range of harmful mycotoxins in the kernels. In order to identify the Fusarium species and their mycotoxin profiles associated to maize ear rot and kernel contamination in Iran, a wide sampling was carried out from field in ten major maize-producing provinces in Iran, during 2015 and 2016. From 182 samples of maize kernels, 551 strains were isolated and identified as belonging to Fusarium genus. Among the 234 representative strains identified at species level by translation elongation factor (EF-1α) sequences, the main Fusarium species were F. verticillioides and F. proliferatum, together representing 90% of the Iranian Fusarium population, and, to a lesser extent, F. incarnatum equiseti species complex (FIESC), F. thapsinum and F. redolens. Fumonisin (FBs) production by F. verticillioides and F. proliferatum representative strains was analysed, showing that all strains produced FB1. None of F. verticillioides strains produced FB2 nor FB3, while both FB2 and FB3 were produced only by F. proliferatum. Total mean of FBs production by F. verticillioides was higher than F. proliferatum. The occurrence of different Fusarium species on Iranian maize is reason of great concern because of the toxigenic risk associated to these species. Moreover, the diversity of the species identified increases the toxigenic risk associated to Fusarium contaminated maize kernels, because of the high possibility that a multi-toxin contamination can occur with harmful consequences on human and animal health.
Authors: Maryam Fallahi, Hossein Saremi, Mohammad Javan-Nikkhah, Stefania Somma, Miriam Haidukowski, Antonio Francesco Logrieco, Antonio Moretti
Keywords: mycotoxin, maize ear rot, fumonisin, trichothecenes, toxigenic risk
Published: 24/05/2019
Repository: https://www.ncbi.nlm.nih.gov/pmc/articles/PMC6563283/
This work has received funding form the the EU’s H2020 research and innovation programme under GA No 678781- MycoKey. CC BY 4.0 license http://creativecommons.org/licenses/by/4.0/
Acid treatment of durian peel changes the morphological structure of its surface and enhances mycotoxin adsorption efficacy. Acid-treated durian peel is a promising waste material for mycotoxin decontamination.
Authors: Saowalak Adunphatcharaphon; Awanwee Petchkongkaew; Donato Greco; Vito D’Ascanio; Wonnop Visessanguan; Giuseppina Avantaggiato
Keywords: mycotoxins; durian peel; agricultural by-products; biosorption; gastrointestinal digestion model; decontamination; equilibrium isotherms
Published: 08/02/2020
Repository: https://europepmc.org/article/MED/32046316?singleResult=true
This work has received funding form the the EU’s H2020 research and innovation programme under GA No 678781- MycoKey.
CC-BY license http://creativecommons.org/
Spent mushroom substrate from Pleurotus eryngii proved to be a suitable source of aflatoxin-degrading enzymes. A crude extract of this by-product of mushroom cultivation is easy to be obtained, not toxic, inexpensive, eco-friendly, and could degrade up to 90% of AFB1, thus qualifying as a potential technology for remediation of contaminated commodities.
Authors: Maria Teresa Branà, Lucrezia Sergio, Miriam Haidukowski, Antonio F. Logrieco, Claudio Altomare
Keywords: Pleurotus eryngi; king oyster mushroom; spent mushroom substrate; crude extract; aflatoxins; laccase; feed detoxification
Published: 14/01/2020
Repository: https://www.ncbi.nlm.nih.gov/pubmed/31947703
This work has received funding form the the EU’s H2020 research and innovation programme under GA No 678781- MycoKey.
CC-BY license http://creativecommons.org/
In this study, we used a Type II CRISPR-Cas9 system to inactivate a key gene in the fumonisin biosynthetic cluster in F. proliferatum. Our working hypotheses were: (i) in-vitro-assembled RNPs could be used with a donor DNA repair template for direct co-transformation of F. proliferatum, and (ii) the FUM1 gene was essential for the synthesis of fumonisin. This work advances the field by providing a new, simple tool for making knockout mutants in members of the F. fujikuroi species complex, and by confirming the essential role of FUM1 in fumonisin biosynthesis in F. proliferatum.
Authors: Ferrara, M., Haidukowski, M., Logrieco, A.F., Leslie, J. F., Mulè, G
Keywords: CRISPR- Cas9; Genome Editing; Fusarium
Published: 27/12/2019
Repository: https://www.ncbi.nlm.nih.gov/pubmed/31882627?dopt=Abstract
This work has received funding form the the EU’s H2020 research and innovation programme under GA No 678781- MycoKey.
CC-BY license http://creativecommons.org/
| Aflatoxins (AFs) are produced mainly by the molds Aspergillus flavus and Aspergillus parasiticus. Aflatoxin B1 (AFB1) is classified as carcinogenic to humans. The aim of this study was to evaluate the capacity of different strains of Lactobacilli (Lb.) and Bifidobacteria (Bf.) to reduce the bioaccessibility of AFB1 and aflatoxin B2 (AFB2), spiked in loaf bread, using a dynamic in vitro simulated gastrointestinal digestion system. Aliquots of 20 mL of gastric and duodenal fluids were sampled for the determination of the mycotoxins gastric and duodenal bioaccessibility respectively, by liquid-chromatography coupled to the mass spectrometry in tandem (LC-MS/MS). A reduction of AFs bioaccessibility compared to the control (digestion without bacterial strains) was evidenced. The strains that evidenced the highest gastric and duodenal bioaccessibility reductions of AFB1 and AFB2 were Lb. johnsoni CECT 289, Lb. reuteri CECT 725, Lb. plantarum CECT 220 and Lb. casei CECT 4180, with values ranging from 76.38 to 98.34% for AFB1 and from 77.14 to 98.66% for AFB2. These results suggest that a food enriched with specific probiotic microorganisms and consumed at the same time as food contaminated with AFs, could reduce the risk associated to the intake of these toxic compounds contained in food. |
Authors: F. Saladino; E. Posarelli; C. Luz; F. B. Luciano; M. T. Rodriguez-Estrada; J. Mañes; G. Meca
Keywords: Aflatoxins; Bioaccessibility; Probiotic bacteria; Lactobacillus Bifidobacterium
Published: 22/01/2017
Repository: https://zenodo.org/record/3531534#.XcP7OjNKiM8
This work has received funding form the the EU’s H2020 research and innovation programme under GA No 678781- MycoKey.
CC-BY-NC-ND license http://creativecommons.org/
Mycotoxins are known worldwide as fungus-produced toxins that adulterate a wide heterogeneity of raw feed ingredients and final products. Consumption of mycotoxins-contaminated feed causes a plethora of harmful responses from acute toxicity to many persistent health disorders with lethal outcomes; such as mycotoxicosis when ingested by animals. Therefore, the main task for feed producers is to minimize the concentration of mycotoxin by applying different strategies aimed at minimizing the risk of mycotoxin effects on animals and human health. Once mycotoxins enter the production chain it is hard to eliminate or inactivate them. This paper examines the most recent findings on different processes and strategies for the reduction of toxicity of mycotoxins in animals. The review gives detailed information about the decontamination approaches to mitigate mycotoxin contamination of feedstuffs and compound feed, which could be implemented in practice.
Authors: Radmilo Čolović ,Nikola Puvača , Federica Cheli ,Giuseppina Avantaggiato ,Donato Greco ,Olivera Đuragić, Jovana Kos, Luciano Pinotti
Keywords: mycotoxins; reduction; grain cleaning; thermal processing; chemicals; adsorbents
Published: 8/8/2019
Repository: https://www.ncbi.nlm.nih.gov/pmc/articles/PMC6891401/
This work has received funding form the the EU’s H2020 research and innovation programme under GA No 678781- MycoKey.
CC-BY license http://creativecommons.org/
The Fusarium incarnatum–equiseti species complex (FIESC) comprises 33 phylogenetically distinct species that have been recovered from diverse biological sources, but have been most often isolated from agricultural plants and soils. Collectively, members of FIESC can produce diverse mycotoxins. However, because the species diversity of FIESC has been recognized only recently, the potential of species to cause mycotoxin contamination of crop plants is unclear. In this study, therefore, we used comparative genomics to investigate the distribution of and variation in genes and gene clusters responsible for the synthesis of mycotoxins and other secondary metabolites (SMs) in FIESC. Results suggest that although the portion of the genome devoted to SM biosynthesis has remained similar during the evolutionary diversification of FIESC, the ability to produce SMs could be affected by the different distribution of related functional and complete gene clusters.
Authors: Alessandra Villani, Robert H. Proctor, Hye-Seon Kim, Daren W. Brown, Antonio F. Logrieco, Maria Teresa Amatulli, Antonio Moretti, Antonia Susca
Repository: https://www.ncbi.nlm.nih.gov/pmc/articles/PMC6480918/
Keywords: Fusarium incarnatum-equiseti species complex, Comparative genome analyses, Secondary metabolite genes, Phylogeny, Horizontal gene transfer-
Published: 24/04/2019
This work has received funding form the the EU’s H2020 research and innovation programme under GA No 678781- MycoKey. CC-BY license http://creativecommons.org/
Fusarium graminearum can cause Giberella Ear Rot (GER) and seedling blight in maize, resulting in major yield losses. Besides GER, the infected grains are consequently contaminated with multiple mycotoxins of F. graminearum. Zearalenone and trichothecenes, such as deoxynivalenol and its acetylated forms, are among the major mycotoxins associated with F. graminearum infection in maize. In the current work, we explored the effect of the endophytic fungal genera of Epicoccum and Sordaria, to control F. graminearum infection in comparative trials with Piriformospora spp., an elusive endophytic genus. Furthermore, we investigated the effect of these endophytes on zearalenone, deoxynivalenol, and 15-acetyldeoxynivalenol levels using in vitro and in planta assays
Authors: Mohamed F. Abdallah, Marthe De Boevre, Sofie Landschoot, Sarah De Saeger, Geert Haesaert, Kris Audenaert
Repository: https://www.ncbi.nlm.nih.gov/pmc/articles/PMC6316275/
Keywords: Fusarium graminearum, biocontrol, mycotoxins, endophytes, biogenic volatiles, deoxynivalenol, zearalenone, biological control, maize
Published: 24/11/2018
This work has received funding form the the EU’s H2020 research and innovation programme under GA No 678781- MycoKey. CC-BY license http://creativecommons.org/
There is a gradual shift from representing a species’ genome by a single reference genome sequence to a pan-genome representation. Pan-genomes are the abstract representations of the genomes of all the strains that are present in the population or species. In this study, we employed a pan-genomic approach to analyze the intraspecific mitochondrial genome diversity of Fusarium graminearum. We present an improved reference mitochondrial genome for F. graminearum with an intron-exon annotation that was verified using RNA-seq data. Each of the 24 studied isolates had a distinct mitochondrial sequence. Length variation in the F. graminearum mitogenome was found to be largely due to variation of intron regions (99.98%).
Authors: Brankovics, B, Kulik, T, Sawicki, J, Bilska, K, Zhang, H, de Hoog, GS, van der Lee, TAJ, Waalwijk, C, van Diepeningen
Keywords: Comparative genomics; Mitogenome; Mitogenomics; Pan-genome; Pool sequencing
Published: 19/12/2018
Repository: https://www.ncbi.nlm.nih.gov/pubmed/30588394
This work has received funding form the the EU’s H2020 research and innovation programme under GA No 678781- MycoKey.
CC-BY license http://creativecommons.org/
Dry beans are a traditional staple food of great economic, social and nutrition importance in Brazil. Seven out of ten Brazilians consume beans daily, irrespective of their income level. Brazil is one of the major global producers of dry beans, with a total of 5.9 million tons harvested in 2016 growing seasons (CONAB – National Supply Company, 2017). A variety of beans from different groups and market classes are grown in Brazil: Groups being the botanical species Phaseolus vulgaris (I) and Vigna unguiculata (II), while the class identifies the beans according to their skin colors (black, white or mixed colors). The cream seeded variety Carioca belongs to group I and is most widely consumed, accounting for approximately 70% of total beans consumed, followed by black beans (several varieties grouped as Preto). Carioca and Preto beans correspond to around 85% of the Brazilian bean market (Ribeiro et al., 2014). Other types of beans are important regional foods, including the Fradinho bean (cowpea), which is popular in Northeastern Brazil, representing approximately 10% of the total Brazilian dry bean market.
Authors: Alves dos Santos-Ciscon, B, van Diepeningen, AD, da Cruz Machado, J, Dias, IE and Waalwijk, C
Keywords: A. flavus; A. niger; A. luchuensis; Aflatoxin; Fumonisin; Ochratoxin A
Published: 10/12/2018
Repository: https://www.wur.nl/en/Library/Researchers/Open-Access/Self-archiving.htm
This work has received funding form the the EU’s H2020 research and innovation programme under GA No 678781- MycoKey. Green Open Access (e.g. self-archiving)
The association research platform MYTOX “Mycotoxins and Toxigenic Moulds” held the 5th meeting of its International Symposium in Ghent, Belgium on 11 May 2016. The Symposium welcomed over 100 scientists, researchers and representatives from industry and government as well as academia to discuss all aspects of mycotoxin research including production, occurrence and detection, the impact on human and animal health, reduction and prevention, toxicology and other topics. Mycotoxins—toxic fungal secondary metabolites—play a significant role in food and feed safety, as well as in medical and environmental microbiology. Indeed, mycotoxins have been shown to be the number one threat amongst food and feed contaminants regarding chronic toxicity. Economic losses are due to effects on livestock productivity and direct losses in crop yield and stored agricultural products. Legislative limits for a range of mycotoxins continue to develop worldwide, resulting in an increased number of official controls deriving from national food safety plans and for food trade purposes. Furthermore, environmental mycotoxins are a continuous threat to human and animal health.
Authors: Sarah De Saeger, Kris Audenaert, Siska Croubels
Keywords: mycotoxins; toxigenic moulds;
Published: 12/05/2016
Repository: http://europepmc.org/articles/PMC4885061
This work has received funding form the the EU’s H2020 research and innovation programme under GA No 678781- MycoKey. CC BY 4.0 license http://creativecommons.org/licenses/by/4.0/
The germ tube burst method (GTBM) was employed to examine karyotypes of 33 Fusarium species representative of 11 species complexes that span the phylogenetic breadth of the genus. The karyotypes revealed that the nucleolar organizing region (NOR), which includes the ribosomal rDNA region, was telomeric in the species where it was discernible. Variable karyotypes were detected in eight species due to variation in numbers of putative core and/or supernumerary chromosomes. The putative core chromosome number (CN) was most variable in the F. solani (CN = 9‒12) and F. buharicum (CN = 9+1 and 18-20) species complexes.
Authors: Cees Waalwijk, Masatoki Taga, Song-Lin Zheng, Robert H. Proctor, Martha M. Vaughan, Kerry O’Donnell
Keywords: accessory, chromosome, genome, NOR, pathogen, phylogeny, qPCR, RPB1, RPB2, supernumerary
Published: 26/02/2018
Repository: https://www.ncbi.nlm.nih.gov/pmc/articles/PMC6048573/
This work has received funding form the the EU’s H2020 research and innovation programme under GA No 678781- MycoKey. CC BY 4.0 license http://creativecommons.org/licenses/by/4.0/
Plant pathogenic fungi in the Fusarium genus cause severe damage to crops, resulting in great financial losses and health hazards. Specialized metabolites synthesized by these fungi are known to play key roles in the infection process, and to provide survival advantages inside and outside the host. However, systematic studies of the evolution of specialized metabolite-coding potential across Fusarium have been scarce. Here, we apply a combination of bioinformatic approaches to identify biosynthetic gene clusters (BGCs) across publicly available genomes from Fusarium, to group them into annotated families and to study gain/loss events of BGC families throughout the history of the genus. Comparison with MIBiG reference BGCs allowed assignment of 29 gene cluster families (GCFs) to pathways responsible for the production of known compounds, while for 57 GCFs, the molecular products remain unknown.
Authors: Koen Hoogendoorn, Lena Barra, Cees Waalwijk, Jeroen S. Dickschat, Theo A. J. van der Lee, Marnix H. Medema
Keywords: biosynthetic gene cluster, Fusarium, koraiol, ancestral state reconstruction (ASR), supernumary chromosome
Published: 05/06/2018
Repository: https://www.ncbi.nlm.nih.gov/pmc/articles/PMC5996196/
This work has received funding form the the EU’s H2020 research and innovation programme under GA No 678781- MycoKey.
CC-BY license http://creativecommons.org/
Fungal infection by Fusarium verticillioides is cause of prevalent maize disease leading to substantial reductions in yield and grain quality worldwide. Maize resistance to the fungus may occur at different developmental stages, from seedling to maturity. The breeding of resistant maize genotypes may take advantage of the identification of quantitative trait loci (QTL) responsible for disease resistance already commenced at seedling level.
Authors: Popi Septiani, Alessandra Lanubile, Lorenzo Stagnati, Matteo Busconi, Hilde Nelissen, Mario Enrico Pè, Matteo Dell’Acqua, Adriano Marocco
Keywords: Fusarium, maize, breeding, QTL
Published: 05/04/2019
Repository: http://europepmc.org/articles/PMC6451006
This work has received funding form the the EU’s H2020 research and innovation programme under GA No 678781- MycoKey. CC BY 4.0 license http://creativecommons.org/licenses/by/4.0/
Since 2013, bentonite in the form of dioctahedral smectite is an additive authorised in the EU as a substance for the reduction of the contamination of feed by aflatoxins. Several studies indicate a big difference in the effectiveness of smectites in sequestering aflatoxins. A clear correlation between mineralogical and physico-chemical properties of smectites and aflatoxin adsorption has not been well established.
Authors: Vito D’Ascanio; Donato Greco; Elena Menicagli; Elisa Santovito; Lucia Catucci; Antonio F.Logrieco; Giuseppina Avantaggiato
Keywords: Aflatoxins; Smectites; Sedimentary bentonites; Hydrothermal bentonites; Adsorption Desorption
Published: 13/07/2019
Repository: https://zenodo.org/record/3666317#.XkVaAGhKiM8 http://eprints.bice.rm.cnr.it/id/eprint/19254
This work has received funding form the the EU’s H2020 research and innovation programme under GA No 678781- MycoKey.
CC BY-NC-ND 4.0 license http://creativecommons.org/
This manuscript reports the first fluorescence polarization immunoassay for the determination of T-2 and HT-2 toxins and relevant glucosides in wheat. Two alternative extraction protocols were proposed and methods were validated in accordance with the Commission Regulation (EU) No. 519/2014.
Authors: Vincenzo Lippolis, Anna C. R. Porricelli, Erminia Mancini, Biancamaria Ciasca, Veronica M. T. Lattanzio, Annalisa De Girolamo, Chris M. Maragos, Susan McCormick, Peiwu Li, Antonio F. Logrieco, Michelangelo Pascale
Keywords: fluorescence polarization immunoassay; T-2 toxin; HT-2 toxin; T-2 glucoside; HT-2 glucoside; wheat; validation study; screening method
Published: 01/07/2019
Repository: https://www.ncbi.nlm.nih.gov/pubmed/31266143
This work has received funding form the the EU’s H2020 research and innovation programme under GA No 678781- MycoKey.
CC-BY license http://creativecommons.org/
Peroxisomes are involved in a wide range of important cellular functions. Here, the role of the peroxisomal membrane protein PEX3 in the plant-pathogen and mycotoxin producer Fusarium graminearum was studied using knock-out and complemented strains. To fluorescently label peroxisomes’ punctate structures, GFP and RFP fusions with the PTS1 and PTS2 localization signal were transformed into the wild type PH- 1 and 1FgPex3 knock-out strains. The GFP and RFP transformants in the 1FgPex3 background showed a diffuse fluorescence pattern across the cytoplasm suggesting the absence of mature peroxisomes.
Authors: Xiangjiu Kong, Hao Zhang, Xiaoliang Wang, Theo van der Lee, Cees Waalwijk, Anne van Diepeningen, Balazs Brankovics, Jin Xu, Jingsheng Xu, Wanquan Chen, Jie Feng
Keywords: FgPex3, Peroxisome Biogenesis Factor, Fusarium graminearum
Published: 20/9/2019
Repository: https://library.wur.nl/WebQuery/wurpubs/554078
This work has received funding form the the EU’s H2020 research and innovation programme under GA No 678781- MycoKey.
CC-BY license http://creativecommons.org/
The influence of climate change on agricultural systems has been generally accepted as having a considerable impact on food security and safety. It is believed that the occurrence of mycotoxins will be greatly affected by future climate scenarios and this has been confirmed by recent data. Temperature (T) and CO2 increases, variation in rain intensity and distribution, as well as extreme weather events, affect the dominant fungal species in different ways, depending on their ecological needs. Therefore, the aim of this work was to study Aspergillus flavus (Af) and Fusarium verticillioides (Fv) co-occurrence in vitro in order to collect quantitative data on the effect of fungal interaction on growth and mycotoxin production and develop functions for their description.
Authors: Marco Camardo Leggieri, Paola Giorni, Amedeo Pietri, Paola Battilani
Keywords: mycotoxin, temperature, co-occurrence, aflatoxin, fumonisin
Published: 12/11/2019
Repository: https://www.ncbi.nlm.nih.gov/pmc/articles/PMC6861442/
This work has received funding form the the EU’s H2020 research and innovation programme under GA No 678781- MycoKey. CC BY 4.0 license http://creativecommons.org/licenses/by/4.0/
In this study, we developed a LAMP assay, based on the detection of fum10, for a rapid and specific molecular detection of FB2-producing A. niger and A. welwistchiae, potentially useful to perform monitoring directly “on site” in maize chain. Results showed that very low amounts of conidia are suitable to detect the presence of the target gene, thus providing information about the presence of FB2-producing Aspergillus species and the possible upcoming fumonisins contamination in maize. The assay was combined with a suitable protocol for “in field” crude DNA extraction and a colorimetric method for easy naked-eye evaluationof results, offering a reliable and user-friendly tool to support effective reduction strategies of mycotoxin contamination in crop management programs.
Authors: Massimo Ferrara, Antonio F. Logrieco, Antonio Moretti, Antonia Susca
Keywords: Aspergillus niger, Aspergillus welwitschiae, Rapid molecular tool, Fumonisin, Maize
Published: 28/02/2020
Repository: https://zenodo.org/record/3752726#.XpboW8gzbIU
This work has received funding form the the EU’s H2020 research and innovation programme under GA No 678781- MycoKey. CC BY 4.0 license http://creativecommons.org/licenses/by/4.0/
Aim of this study is to evaluate biological control agents (BCAs) against Fusarium graminearum on infected maize stalks as a means to reduce Fusarium head blight (FHB) in subsequently grown wheat. The findings support the application of C. rosea against F. graminearum on residues of maize to suppress the primary inoculum of FHB. SIGNIFICANCE AND IMPACT OF THE STUDY:As sustainable agriculture requires solutions to control FHB, hence, the application of C. rosea during the mulching of maize crop residues should be evaluated in on-farm experiments.
Authors: A. Gimeno, A. Kagi, D. Drakopoulos, I. Banziger , E. Lehmann1 , H.-R. Forrer , B. Keller and S. Vogelgsang
Keywords: Fusarium graminearum, Mycotoxins, Biological control
Published: 01/02/2020
Repository: https://europepmc.org/article/med/32176428
CC-BY license http://creativecommons.org/
The objective of this study was to assess prevention measures with potential to suppress F. graminearum and decrease mycotoxin contamination in wheat in a simulated maize-wheat rotation under notillage. Within this context, the effects of applying mulch layers or botanical extracts onto artificially inoculated maize residues with F. graminearum were investigated. We examined a cut-and-carry approach meaning that cover crops were cultivated in separate fields and transferred to the wheat crop in order to cover the maize residues.
Authors: Dimitrios Drakopoulos, Andreas Kägi , Alejandro Gimeno, Johan Six , Eveline Jenny , Hans-Rudolf Forrer , Tomke Musa , Giuseppe Meca , Susanne Vogelgsang
Keywords: Fusarium graminearum Mycotoxin Wheat Mustard Clover
Published: 01/02/2020
Repository: https://ira.agroscope.ch/en-US/publication/42988
CC-BY license http://creativecommons.org/
The main objective of this study was to test the efficacy of mustard-based botanicals to reduce F. graminearum infection and mycotoxin accumulation in wheat. As a first step, the effects of botanicals at different concentrations were tested using a mycelium growth in vitro bioassay. Secondly, the efficacy of the botanicals was investigated under controlled conditions in the growth chamber using wheat plants that were artificially inoculated, with either conidia or ascospores. Subsequently, the efficacy of the botanicals was tested under field conditions in a wheat crop using a semi-artificial inoculation method with F. graminearum. Finally, the GSLs, ITCs, and phenolic acids present in the botanical powders were identified and quantified.
Authors: Dimitrios Drakopoulos, Giuseppe Meca, Raquel Torrijos, Anja Marty, Andreas Kägi, Eveline Jenny, Hans-Rudolf Forrer, Johan Six and Susanne Vogelgsang
Keywords: Fusarium head blight, antifungal botanical, isothiocyanate, phenolic acid, mycotoxin, conidia, ascospores, wheat
Published: 21/07/2020
Repository: https://www.ncbi.nlm.nih.gov/pmc/articles/PMC7396492/
CC-BY license http://creativecommons.org/
Fusarium head blight (FHB) is one of the most important cereal diseases worldwide, causing yield losses and contamination of harvested products with mycotoxins. Fusarium graminearum is one of the most common FHB-causing species in wheat and barley cropping systems. We assessed the ability of different botanical extracts to suppress essential stages of the fungal life cycle using three strains of F. graminearum (FG0410, FG2113, and FG1145). The botanicals included aqueous extracts from white mustard (Sinapis alba) seed flour (Pure Yellow Mustard [PYM] and Tillecur [Ti]) as well as milled Chinese galls (CG). At 2% concentration (wt/vol), PYM and Ti completely inhibited growth of mycelium of all F. graminearum strains whereas, at 1%, CG reduced the growth by 65 to 83%, depending on the strain. While PYM and Ti reduced the germination of both conidia and ascospores at 2% (wt/vol), CG was only effective in reducing conidia germination. Perithecia formation of FG0410 but not FG2113 was suppressed by all botanicals. Moreover, application of botanicals on mature perithecia led to a two- to fourfold reduction in discharge of ascospores. Using liquid chromatography (LC) with diode array detection, we quantified the principal glucosinolate component sinalbin of PYM and Ti. LC time-of-flight mass spectrometry was used to demonstrate that the bioactive matrix of CG contains different gallotannins as well as gallic and tannic acids. Possible antifungal mechanisms of the botanical matrices are discussed. The results of this study are promising and suggest that PYM, Ti, and CG should be explored further for efficacy at managing FHB
Authors: Dimitrios Drakopoulos , Carlos Luz , Raquel Torrijos , Giuseppe Meca , Pascal Weber , Irene Bänziger , Ralf T Voegele , Johan Six , Susanne Vogelgsang
Keywords: Fusarium graminearum; biological control; botanicals; disease control; mycology
Published: 10/10/2019
Repository: https://pubmed.ncbi.nlm.nih.gov/31600112/
CC-BY license http://creativecommons.org/
The Fusarium fujikuroi species complex (FFSC) and F. oxysporum species complex (FOSC) are two related groups of plant pathogens causing a wide diversity of diseases in agricultural crops world wide. The aims of this study are (1) to clarify the phylogeny of the FFSC, (2) to identify potential deviation from tree-like evolution, (3) to explore the value of using mitogenomes for these kinds of analyses, and (4) to better understand mitogenome evolution. In total, we have sequenced 24 species from the FFSC and a representative set of recently analyzed FOSC strains was chosen, while F. redolens was used as outgroup for the two species complexes. A species tree was constructed based on the concatenated alignment of seven nuclear genes and the mitogenome, which was contrasted to individual gene trees to identify potential conflicts. These comparisons indicated conflicts especially within the previously described African clade of the FFSC. Furthermore, the analysis of the mitogenomes revealed the presence of a variant of the large variable (LV) region in FFSC which was previously only reported for FOSC. The distribution of this variant and the results of sequence comparisons indicate horizontal genetic transfer between members of the two species complexes, most probably through introgression. In addition, a duplication of atp9 was found inside an intron of cob, which suggests that even highly conserved mitochondrial genes can have paralogs. Paralogization in turn may lead to inaccurate single gene phylogenies. In conclusion, mitochondrial genomes provide a robust basis for phylogeny. Comparative phylogenetic analysis indicated that gene flow among and between members of FFSC and FOSC has played an important role in the evolutionary history of these two groups. Since mitogenomes show greater levels of conservation and synteny than nuclear regions, they are more likely to be compatible for recombination than nuclear regions. Therefore, mitogenomes can be used as indicators to detect interspecies gene flow.
Authors: Balázs Brankovics, Anne D. van Diepeningen, G. Sybren de Hoog, Theo A. J. van der Lee,andCees Waalwijk
Keywords: mitogenomics, introgression, Fusarium oxysporum species complex, F. fujikuroi species complex, phylogenetics, horizontal gene transfer
Published: 03/06/2020
Repository: https://www.ncbi.nlm.nih.gov/pmc/articles/PMC7285627/
This work has received funding form the the EU’s H2020 research and innovation programme under GA No 678781- MycoKey.
CC-BY license http://creativecommons.org/
A total of 129 wheat cultivars collected from local breeders in four ecological regions in China was evaluated for Fusarium head blight resistance after natural infection under epidemic conditions. The disease index was scored and seven toxins concentrations were determined by UPLC-MS/MS. The disease index ranged from 6.3 to 80.9% and a strong correlation was found between the regions from which the cultivars originate and disease index. The middle and lower reaches of Yangtze River Region showed the highest disease resistance, followed by the upper reaches of the Yangtze River Region. FHB resistance of cultivars from northern and southern Huanghuai Region was lowest and all cultivars in these regions are highly or moderately susceptible. Disease index was significantly correlated with toxin accumulation on nation scale, but no clear correlation was found within most ecological regions. The toxin accumulation was also not well correlated with resistant levels. As the incidence of FHB has increased dramatically over the last decade, improved FHB resistance in cultivars is urgently needed. We recommend that besides scoring for disease index also mycotoxin accumulation in cultivars is incorporated in breeding procedures and the evaluation of cultivars.
Authors: Z. Yan, H. Zhang1, T.A.J. van der Lee, C. Waalwijk, A.D. van Diepeningen, Y. Deng5, J. Feng, T. Liu and W. Chen
Keywords: Fusarium, head blight, resistance, toxin, disease index, wheat
Published: 17/12/2019
Repository: https://research.wur.nl/en/publications/resistance-to-fusarium-head-blight-and-mycotoxin-accumulation-amo
This work was supported by the National Key R&D Program of China (2018YFD0200500, 2017YFE0126700, 2016YFE0112900) and the European Union’s Horizon 2020 research and innovation programme under grant agreement No. 678781 (MycoKey) and from the Fundamental Research Funds for Central Non-profit Scientific Institution (Y2017XM01).
Maize is the principal staple food/feed crop exposed to mycotoxins, and the co-occurrence of multiple mycotoxins and their metabolites has been well documented. This review presents the infection cycle, ecology, and plant-pathogen interactions of Aspergillus and Fusarium species in maize, and current knowledge on maize chain management to mitigate the occurrence of aflatoxins and fumonisins. Preventive actions include at pre-harvest, as part of cropping systems, at harvest, and at post-harvest, through storage, processing, and detoxification to minimize consumer exposure. Preventive actions in the field have been recognized as efficient for reducing the entrance of mycotoxins into production chains. Biological control of Aspergillus flavus has been recognized to minimize contamination with aflatoxins. Post-harvest maize grain management is also crucial to complete preventive actions, and has been made mandatory in government food and feed legislation.
Authors: R. Palumbo, A. Gonçalves, A. Gkrillas, A. Logrieco, J.-L. Dorne, C. Dall’Asta, A. Venâncio, P. Battilani
Keywords: Aspergillus, Fusarium, aflatoxins, fumonisins, deoxynivalenol
Published: 30/09/2019
Repository: http://repositorium.sdum.uminho.pt/handle/1822/65786
This work has received funding form the the EU’s H2020 research and innovation programme under GA No 678781- MycoKey.
Maize is a possible host of many fungi, some of them able to produce different mycotoxins. Few studies exist on co-occurring fungi and resulting multi-mycotoxin contamination in field; for this reason, in field trials were conducted in two consecutive years to verify fungal incidence and mycotoxin production in the case of the co-occurrence of the three main mycotoxigenic fungi of maize in Italy: Aspergillus flavus, Fusarium verticillioides, and Fusarium graminearum able to produce, respectively, aflatoxin B1 (AFB1), fumonisins (FBs), and deoxynivalenol (DON). Artificial inoculation was done after silk emergence of maize and samples were collected with a 2 week schedule up to harvest time (four samplings). Fungal interaction resulted as playing a role for both fungal incidence and mycotoxins production, as did weather conditions too. Main interactions were noted between A. flavus and F. verticillioides, and between F. verticillioides and F. graminearum. In particular, as a result of fungal co-occurrence, AFB1 resulted stimulated by F. graminearum presence while no effects were noted in FBs and DON in case of F. verticillioides–F. graminearum co-occurrence. Interestingly, the co-presence of A. flavus significantly reduced both FB and DON production.
Authors: Paola Giorni, Terenzio Bertuzzi, Paola Battilani
Keywords: maize, Fusarium verticillioides, Fusarium graminearum, Aspergillus flavus, aflatoxin, fumonisin, deoxynivalenol
Published: 06/06/2019
Repository: https://www.ncbi.nlm.nih.gov/pmc/articles/PMC6563760/
This work has received funding form the the EU’s H2020 research and innovation programme under GA No 678781- MycoKey.
In the current study, we developed a quantitative real-time PCR detection method that amends the currently available culture-dependent techniques by using TaqMan chemistry with a highly specific primer and probe set, targeting the actin gene. We established a sensitive assay that detects the biological control agent down to 100 genome copies per reaction, with PCR efficiencies between 90 and 100%. The specificity of the assay was confirmed against a panel of 30 fungal and 3 bacterial species including 12 members of the Fusarium head blight complex and DNA of barley, maize and wheat.
Authors: Alejandro Gimeno1, Elina Sohlberg, Tiina Pakula, Jenni Limnell, Beat Keller, Arja Laitila, Susanne Vogelgsang
Keywords: TaqManq; PCR; Clonostachys rosea; Fusarium graminearum
Published: 16/07/2019
Repository: https://www.ncbi.nlm.nih.gov/pmc/articles/PMC7020406/
This work has received funding form the the EU’s H2020 research and innovation programme under GA No 678781- MycoKey. CC BY 4.0 license http://creativecommons.org/licenses/by/4.0/
The qualitative antifungal effect of cell-free supernatant (CFS) obtained by L. plantarum spp. fermentation was determined by halo inhibition test on the solid medium of potato dextrose agar (PDA). The analyses of results demonstrated that all evaluated strains of L. plantarum fermented MRS, and their CFS possessed antifungal effect (Table 1). Regarding the L. plantarum CECT 749, its CFS showed the highest halo inhibition zone against the strain of F. graminearum ITEM 126, F. cerealis CECT 20489, F. verticillioides CECT 2152, F. verticillioides CECT 2982, and A. flavus ITEM 8111 in comparison to others. Moreover, the strains of F. verticillioides showed higher sensitivity towards L. plantarum CECT 749 CFS related to other fungi.
Authors: Tiago de Melo Nazareth, Carlos Luz, Raquel Torrijos, Juan Manuel Quiles, Fernando Bittencourt Luciano, Jordi Mañes, Giuseppe Meca
Keywords: Lactobacillus plantarum, aflatoxin B1, fumonisin B1, biopreservation
Published: 31/12/2019
Repository: https://www.ncbi.nlm.nih.gov/pmc/articles/PMC7020406/
This work has received funding form the the EU’s H2020 research and innovation programme under GA No 678781- MycoKey. CC BY 4.0 license http://creativecommons.org/licenses/by/4.0/
Aspergillus flavus, the main aflatoxin B1 producing fungal species, Fusarium graminearum, a deoxynivalenol producer, and the fumonisin-producing species F. proliferatum and F. verticillioides are the main toxigenic fungi (TF) that colonize maize. Several strategies are available to control TF and related mycotoxins, such as chemical control. However, there is poor knowledge on the efficacy of fungicides on maize plants since few molecules are registered. The sensitivity of F. graminearum, F. proliferatum, F. verticillioides, and A. flavus to eleven fungicides, selected based on their different modes of action, was evaluated in both in vitro assays and, after selection, in the field. In vitro, demethylation inhibitors (DMI) showed excellent performances, followed by thiophanate-methyl and folpet. Among the succinate dehydrogenase inhibitors (SDHI), isopyrazam showed a higher effectiveness against Fusarium species than boscalid, which was ineffective against Fusarium, like the phenyl-pyrrole fludioxonil. Furthermore, both SDHIs and fludioxonil were more active against A. flavus than Fusarium species. In field trials, prothioconazole and thiophanate-methyl were confirmed to be effective to reduce F. graminearum (52% and 48%) and F. proliferatum contamination (44% and 27%). On the other hand, prothioconazole and boscalid could reduce A. flavus contamination at values of 75% and 56%, respectively
Authors: Mario Masiello , Stefania Somma , Veronica Ghionna , Antonio Francesco Logrieco , Antonio Moretti
Keywords: Demethylation Inhibitors; SDHI-resistance; boscalid; fludioxonil; maize ear rot disease control; prothioconazole
Published: 01/01/2019
Repository: https://pubmed.ncbi.nlm.nih.gov/30609646/
This work has received funding form the the EU’s H2020 research and innovation programme under GA No 678781- MycoKey. CC BY 4.0 license http://creativecommons.org/licenses/by/4.0/
This review investigated the main compounds with antifungal and anti-aflatoxigenic activity, also elucidating their physiological role and the different modes of action and synergies. Plant bioactive compounds are shown to be effective in modulating Aspergillus spp. contamination and AF production both in vitro and in vivo. Therefore, their application in pre- and postharvest management could represent an important tool to control aflatoxigenic fungi and to reduce AF contamination.
Authors: Martina Loi, Costantino Paciolla, Antonio F. Logrieco, Giuseppina Mulè
Keywords: Aspergillus, aflatoxins, reduction, bioactive compounds, plant extracts
Published: 12/03/2020
Repository: https://www.ncbi.nlm.nih.gov/pmc/articles/PMC7080658/
This work has received funding form the the EU’s H2020 research and innovation programme under GA No 678781- MycoKey. CC BY 4.0 license http://creativecommons.org/licenses/by/4.0/
The current study aimed to identify Aspergillus species occurring in the rhizosphere of sugarcane in the South of Iran, and to investigate their mycotoxin profiles. One-hundred and twenty-five Aspergillus strains were isolated from the soil of eight major sugarcane-producing sites, and were molecularly identified using sequences of partial β-tubulin (benA) and partial calmodulin (CaM) genes. Our molecular and phylogenetic results showed that around 70% of strains belonged to the Aspergillus section Nigri, and around 25% of species belonged to the Aspergillus section Terrei. Species belonging to both sections are able to produce different mycotoxins.
Authors: Maryam Tavakol Noorabadi, Valiollah Babaeizad, Rasoul Zare, Bita Asgari, Miriam Haidukowski, Filomena Epifani, Gaetano Stea, Antonio Moretti,, Antonio Francesco Logrieco, and Antonia Susca
Keywords: Beta-tubulin, calmodulin, fumonisins, ochratoxin A, patulin, mycotoxin, sugarcane, Aspergillus
Published: 14/02/2020
Repository: https://www.ncbi.nlm.nih.gov/pmc/articles/PMC7076768/
This work has received funding form the the EU’s H2020 research and innovation programme under GA No 678781- MycoKey. CC BY 4.0 license http://creativecommons.org/licenses/by/4.0/
The results showed a shelf life increase of two and three days with the employment of 33 and 50 mg/g of OMF, with a significant reduction of the fungal population (3.1 and 5.7 logs, respectively) in comparison with the control experiment. The use of 16 and 33 mg/g of OMF in the sauce formulation decreased the concentration of OTA in the bread samples while no OTA production was detected employing 50 mg/g of OMF.
Authors: Raquel Torrijos , Tiago M Nazareth , Júlia Pérez , Jordi Mañes , Giuseppe Meca
Keywords: AITC; OTA; active packaging; antifungal properties; bread; shelf life.
Published: 14/03/2019
Repository: https://pubmed.ncbi.nlm.nih.gov/30875724/
This work has received funding form the the EU’s H2020 research and innovation programme under GA No 678781- MycoKey. CC BY 4.0 license http://creativecommons.org/licenses/by/4.0/
Different batches of biomass/feed quality maize contaminated by aflatoxins were processed at the industrial scale (a continuous process and separate discontinuous steps) to evaluate the effect of different cleaning solutions on toxin reduction. The investigated cleaning solutions included: (i) mechanical size separation of coarse, small and broken kernels, (ii) removal of dust/fine particles through an aspiration channel, (iii) separation of kernels based on gravity and (iv) optical sorting of spatial and spectral kernel defects. Depending on the sampled fraction, dynamic or static sampling was performed according to the Commission Regulation No. 401/2006 along the entire cleaning process lines. Aflatoxin analyses of the water–slurry aggregate samples were performed according to the AOAC Official Method No. 2005.008 based on high-performance liquid chromatography and immunoaffinity column cleanup of the extracts. A significant reduction in aflatoxin content in the cleaned products, ranging from 65% to 84% with respect to the uncleaned products, was observed when continuous cleaning lines were used. Additionally, an overall aflatoxin reduction from 55% to 94% was obtained by combining results from separate cleaning steps. High levels of aflatoxins (up to 490 µg/kg) were found in the rejected fractions, with the highest levels in dust and in the rejected fractions from the aspirator and optical sorting. This study shows that a cleaning line combining both mechanical and optical sorting technologies provides an efficient solution for reducing aflatoxin contamination in maize.
Authors: Pascale M., Logrieco A. F., Graeber M., Hirschberger M., Reichel M., Lippolis V., De Girolamo A., Lattanzio V.M. T., Slettengren K.
Keywords: grain cleaning; maize; aflatoxins; remediation; mechanical cleaning; optical sorting
Published: 17/05/2020
Repository: https://zenodo.org/record/3842706#.XsuSwGgzbIU
This work has received funding form the the EU’s H2020 research and innovation programme under GA No 678781- MycoKey. CC BY 4.0 license http://creativecommons.org/licenses/by/4.0/
Fusarium verticillioides infects maize, causing ear rot, yield loss and contamination by fumonisin mycotoxins. The fungus can be transmitted via kernels and cause systemic infection in maize. Maize resistance to the fungus may occur at different developmental stages, from seedling to maturity.
Authors: Stagnati L, Lanubile A, Samayoa, LF, Bragalanti, M, Giorni, P, Busconi, M, Holland, JB, Marocco A
Keywords:
Published: 01/02/2019
Repository: https://www.ncbi.nlm.nih.gov/pubmed/30567831
This work has received funding form the the EU’s H2020 research and innovation programme under GA No 678781- MycoKey.
CC-BY license http://creativecommons.org/
This study shows that biosorbent materials obtained from the mycelium of the mushroom P. eryngii could be used as a low-cost and effective feed additive for AfB1 detoxification.
Authors: Haidukowski M, Casamassima E, Cimmarusti MT, Branà MT, Longobardi F, Acquafredda P, Logrieco A and Altomare C
Keywords: biosorption, aflatoxin, Pleurotus eryngii, feed additive, king oyster mushroom
Published: 25/06/2019
Repository: http://europepmc.org/article/MED/31293538
This work has received funding form the the EU’s H2020 research and innovation programme under GA No 678781- MycoKey.
CC-BY license http://creativecommons.org/
Deoxynivalenol (DON) is a mycotoxin produced in cereal crops infected with Fusarium graminearum. DON poses a serious threat to human and animal health and is a critical virulence factor. Various environmental factors including reactive oxygen species (ROS) have been shown to interfere with DON biosynthesis in this pathogen. The regulatory mechanisms of how ROS trigger DON production have been extensively investigated in F. graminearum.
Authors: Tang G1, Zhang C1,2, Ju Z1, Zheng S1, Wen Z1, Xu S1, Chen Y1, Ma Z1.
Keywords: Fusarium graminearum; Endogenous reactive oxygen species; FgLetm1; Mitochondrial integrity; Mycotoxin; Virulence
Published: 27/10/2017
Repository: http://europepmc.org/article/MED/29077257
This research was supported by the Ministry of Science and Technology of China MOST (2016YFE0112900)
Fungal growth inhibition and aflatoxins (AFs) reduction using allyl (AITC), benzyl (BITC) and phenyl (PITC) isothiocyanates were studied in loaf bread contaminated with Aspergillus parasiticus. Two inoculated loaf bread slices were introduced into a plastic tray together with paper filters or small plastic bags paper filters soaked with AITC, BITC or PITC, the final concentration inside the package was of 0.5, 1 or 5 μL/L.
Authors: Federica Saladino, Juan Manuel Quiles, Fernando B.Luciano, Jordi Mañes, Mónica Fernández-Franzón, Giuseppe Meca
Repository: https://zenodo.org/record/1157969
Keywords: Aspergillus spp.; Loaf bread; Isothiocyanates; Shelf life improvements; Aflatoxin reduction
Published: 27/12/2016
This work has received funding form the the EU’s H2020 research and innovation programme under GA No 678781- MycoKey.
CC-BY-NC-ND-4.0 license http://creativecommons.org/
In this study, 80 commercial samples of bread loaves were purchased from different supermarkets located in Valencia (Spain). These samples were investigated for the presence of legislated and non-legislated mycotoxins. Results showed that samples were contaminated with Aflatoxins (AFs), Zearalenone (ZEA) and Enniatins (ENs) with a frequency of 20, 96, and 65% respectively. Aflatoxin B1 (AFB1), Aflatoxin B2 (AFB2) and Aflatoxin G1 (AFG1) were detected with concentrations ranged from 0.5 to 7.1 μg/kg. The samples contaminated with AFB1 showed values exceeding the maximum limit allowed in the EU.
Authors: FedericaSaladino; Juan ManuelQuiles; Jordi Mañes; MónicaFernández-Franzón; Fernando Bittencourt Luciano; GiuseppeMecaa
Repository: https://zenodo.org/record/1123246
Keywords: Mycotoxins; LC-MS/MS; Loaf bread; Risk assessment; Estimated daily intake
Published: 13/10/2017
This work has received funding form the the EU’s H2020 research and innovation programme under GA No 678781- MycoKey.
CC-BY license http://creativecommons.org/
The impact of climate change has been identified as an emerging issue for food security and safety, and the increased incidence of mycotoxin contamination in maize over the last two decades is considered a potential emerging hazard. Disease control by chemical and agronomic approaches is often ineffective and increases the cost of production; for this reason the exploitation of genetic resistance is the most sustainable method for reducing contamination. The review focuses on the significant advances that have been made in the development of transcriptomic, genetic and genomic information for maize, Fusarium verticillioides molds, and their interactions, over recent years. Findings from transcriptomic studies have been used to outline a specific model for the intracellular signaling cascade occurring in maize cells against F. verticillioides infection.
Authors: Lanubile A, Maschietto V, Borrelli VM, Stagnati L, Logrieco AF, Marocco A.
Keywords:
Published: 12/10/2017
Repository: https://www.ncbi.nlm.nih.gov/pmc/articles/PMC5644281/
This work has received funding form the the EU’s H2020 research and innovation programme under GA No 678781- MycoKey.
CC-BY license http://creativecommons.org/
Fusarium head blight is a disease caused by a complex of Fusarium species. F. poae is omnipresent throughout Europe in spite of its low virulence. In this study, we assessed a geographically diverse collection of F. poae isolates for its genetic diversity using AFLP (Amplified Fragment Length Polymorphism). Furthermore, studying the mating type locus and chromosomal insertions, we identified hallmarks of both sexual recombination and clonal spread of successful genotypes in the population. Despite the large genetic variation found, all F. poae isolates possess the nivalenol chemotype based on Tri7 sequence analysis. Nevertheless, Tri gene clusters showed two layers of genetic variability
Authors:Vanheule A; De Boevre M; Bekaert B; Moretti A; Scauflaire J; Munaut, F; Höfte M; De Saeger, S; Haesaert G; Waalwijk C; van der Lee T; Audenaert K.
Keywords: Fusarium; AFLP; trichothecenes; transposable element; mating type; meiosis
Published: 23/8/2017
Repository: https://www.ncbi.nlm.nih.gov/pmc/articles/PMC5618188/
This work has received funding form the the EU’s H2020 research and innovation programme under GA No 678781- MycoKey.
CC-BY license http://creativecommons.org/
Recent advances confirm the focus in modeling mycotoxin in few crops; cereals, both small grains and maize, deserve major attention. Deoxinivalenol is still the mycotoxin of major interest in wheat, with some studies developed on T-2 and HT-2 toxins. Regarding maize, after fumonisins, the interest moved to aflatoxins. Minor efforts were devoted to aflatoxin contamination in nuts and ochratoxin A in grapes. Weather data are the main driving variables used as input in all modeling approaches, in empiric models commonly supported by cropping data. Few example of mechanistic models were developed, but they seem more promising in the future, when climate change is expected to significantly impact on mycotoxins.
Authors: Battilani P.
Keywords:
Published: 3/9/2016
Repository: https://www.zenodo.org/record/161680
This work has received funding form the the EU’s H2020 research and innovation programme under GA No 678781- MycoKey.
CC-BY license http://creativecommons.org/
This study investigates the use of E-PL as natural antimicrobial to inhibit fungal growth and to reduce aflatoxins (AFs) production. Antifungal activity of starch biofilms with different concentrations of E-Poly-L-lysine (E-PL) was determined in solid medium against Aspergillus parasiticus (AFs producer) and Penicillium expansum. Then, biofilms were tested as antimicrobial devices for the preservation of bread loaf inoculated with A. parasiticus CECT 2681 and P. expansum CECT 2278.
Authors: C. Luz, J. Calpe, F. Saladino, Fernando B. Luciano, M. Fernandez-Franzon, J. Manes, G. Meca
Keywords: E-Poly-L-lysine, aflatoxins, antimicrobial packaging, E-PL biofilms
Published: 12/10/2017
Repository: https://zenodo.org/record/1013427
This work has received funding form the the EU’s H2020 research and innovation programme under GA No 678781- MycoKey.
CC-BY license http://creativecommons.org/
The mitochondrial recombination indicates the presence of a parasexual cycle in F. oxysporum. The obstacles hindering the usage of the mitogenomes are resolved by using next generation sequencing and selective genome
assemblers, such as GRAbB. Complete mitogenome sequences offer a stable basis and reference point for phylogenetic and population genetic studies.
Authors: Balázs Brankovics, Peter van Dam, Martijn Rep, G. Sybren de Hoog, Theo A. J. van der Lee, Cees Waalwijk and Anne D. van Diepeningen.
Repository: http://europepmc.org/articles/PMC5604515
Keywords: Comparative genomics, Mitochondrial genome, Mitochondrial recombination, Phylogenomics
Published: 18/09/2017
This work has received funding form the the EU’s H2020 research and innovation programme under GA No 678781- MycoKey.
CC-BY license http://creativecommons.org/
This paper investigated the capability of the white-rot and edible fungus Plerotus eryngii (king oyster mushroom) to degrade AFB1 both in vitro and in a laboratory-scale mushroom cultivation, using a substrate similar to that routinely used in mushroom farms.
Authors: Maria Teresa Branà; Maria Teresa Cimmarusti; Miriam Haidukowski; Antonio Francesco Logrieco; Claudio Altomare
Keywords: mycotoxin, aflatoxin B1 (AFB1), Plerotus eryngii, detoxification
Published: 3/8/2017
Repository: https://zenodo.org/record/884435
This work has received funding form the the EU’s H2020 research and innovation programme under GA No 678781- MycoKey.
CC-BY license http://creativecommons.org/
This paper investigates the potential role of P. eryngii in the decontamination of FB1 in maize. Selected antioxidant enzymes, (soluble peroxidase (POD), catalase (CAT) and ascorbate peroxidase), primarily involved in control of cell hydrogen peroxide levels, and lignin degradation, were analyzed, to evaluate their contributions to the molecular mechanisms of FB1 by P. eryngii.
Authors: Miriam Haidukowski; Giuseppe Cozzi; Nunzio Dipierro; Simona L. Bavaro; Antonio F. Logrieco; Costantino Paciolla
Keywords: fungal strains, fumonisin B1, hydrogen peroxide, decontamination, mycotoxins.
Published: 10/05/2017
Repository: https://www.zenodo.org/record/574663
This work has received funding form the the EU’s H2020 research and innovation programme under GA No 678781- MycoKey.
CC-BY license http://creativecommons.org/
Mycotoxins are toxic metabolites produced by fungi. To mitigate mycotoxins in food or feed, biotransformation is an emerging technology in which microorganisms degrade toxins into non-toxic metabolites. To monitor deoxynivalenol (DON) biotransformation, analytical tools such as ELISA and liquid chromatography coupled to tandem mass spectrometry (LC-MS/MS) are typically used. However, these techniques do not give a decisive answer about the remaining toxicity of possible biotransformation products. Hence, a bioassay using Lemna minor L. was developed.
Authors: Vanhoutte I; De Mets L; De Boevre M; Uka V; Di Mavungu JD; De Saeger S; De Gelder L; Audenaert K.
Keywords: deoxynivalenol (DON); Lemna minor; bioassay; biotransformation; detoxification; 3-epi-DON; 3-epi-de-epoxy-DON (3-epi-DOM-1)
Published: 13/02/2017
Repository: https://biblio.ugent.be/publication/8512245
This work has received funding form the the EU’s H2020 research and innovation programme under GA No 678781- MycoKey.
CC-BY license http://creativecommons.org/
This review focuses on the biotransformation of mycotoxins performed with purified enzymes isolated from bacteria, fungi and plants, whose activity was validated in in vitro and in vivo assays, including patented ones and commercial preparations. Furthermore, we will present some applications for detoxifying enzymes in food, feed, biogas and biofuel industries, describing their limitation and potentialities.
Authors: Martina Loi, Francesca Fanelli, Vania C. Liuzzi, Antonio F. Logrieco, Giuseppina Mulè
Repository: https://zenodo.org/record/466207
Keywords: mycotoxins; biotransformation; degradation; enzymes; application
Published: 24/03/2017
This work has received funding form the the EU’s H2020 research and innovation programme under GA No 678781- MycoKey.
CC-BY license http://creativecommons.org/
In this study, we analyzed the primary structure of ESYN1 by sequencing esyn1 transcripts from different Fusarium species. Members of the fungal genus Fusarium can produce numerous secondary metabolites, including the nonribosomal mycotoxins beauvericin (BEA) and enniatins (ENNs). Both mycotoxins are synthesized by the multifunctional enzyme enniatin synthetase (ESYN1) that contains both peptide synthetase and S-adenosyl-l-methionine-dependent N-methyltransferase activities.
Authors: Vania C. Liuzzi, Valentina Mirabelli, Maria Teresa Cimmarusti, Miriam Haidukowski, John F. Leslie, Antonio F. Logrieco, Rocco Caliandro,Francesca Fanelli, Giuseppina Mulè.
Repository: https://www.zenodo.org/record/264018
Keywords: enniatin; beauvericin; ESYN1; mycotoxins; Fusarium; homology modelling; multivariate analysis; backbone angles
Published: 25/01/2017
This work has received funding form the the EU’s H2020 research and innovation programme under GA No 678781- MycoKey.
CC-BY license http://creativecommons.org/
An unprecedented, environmentally friendly, and faster method for the determination of Ochratoxin A (OTA) has for the first time, been set up and validated using choline chloride (ChCl)-based deep eutectic solvents (DESs) (e.g., ChCl/glycerol (1:2) and ChCl/ urea (1:2) up to 40% (w/w) water) as privileged, green, and biodegradable extraction solvents.
Authors: Luca Piemontese, Filippo Maria Perna, Antonio Logrieco, Vito Capriati, Michele Solfrizzo.
Repository: https://www.zenodo.org/record/252327
Keywords: deep eutectic solvents; Ochratoxin A; food chemistry; analytical method; green solvents
Published: 12/01/2017
This work has received funding form the the EU’s H2020 research and innovation programme under GA No 678781- MycoKey.
CC-BY license http://creativecommons.org/
Authors: Martina Loi, Francesca Fanelli, Paolo Zucca, Vania C. Liuzzi , Laura Quintieri, Maria T. Cimmarusti, Linda Monaci, Miriam Haidukowski, Antonio F. Logrieco, Enrico Sanjust, Giuseppina Mulè.
Keywords: laccase; Pleurotus; mycotoxins; aflatoxin B1; aflatoxin M1; biodegradation; redox mediators
Published: 23/8/2016
Repository: https://www.zenodo.org/record/161671
This work has received funding form the the EU’s H2020 research and innovation programme under GA No 678781- MycoKey.
CC-BY license http://creativecommons.org/
Degradation of toxins by microorganisms is a promising approach for detoxification of agricultural products. Here, a bacterial strain, Sphingomonas S3-4, that has the ability to degrade the mycotoxin deoxynivalenol (DON) was isolated from wheat fields. Incubation of Fusarium-infected wheat grains with S3-4 completely eliminated DON. In S3-4 DON is catabolized into compounds with no detectable phytotoxicity, 3-oxo-DON and 3-epi-DON, via two sequential reactions. Comparative analysis of genome sequences from two DON-degrading strains, S3-4 and Devosia D17, and one non-DON-degrading strain, Sphingobium S26, combined with functional screening of a S3-4 genomic BAC library led to the discovery that a novel aldo/keto reductase superfamily member, AKR18A1, is responsible for oxidation of DON into 3-oxo-DON. DON-degrading activity is completely abolished in a mutant S3-4 strain where the AKR18A1 gene is disrupted. Recombinant AKR18A1 protein expressed in Escherichia coli catalyzed the reversible oxidation/reduction of DON at a wide range of pH values (7.5 to 11) and temperatures (10 to 50 °C). The S3-4 strain and recombinant AKR18A1 also catabolized zearalenone and the aldehydes glyoxal and methyglyoxal. The S3-4 strain and the AKR18A1 gene are promising agents for the control of Fusarium pathogens and detoxification of mycotoxins in plants and in food/feed products.
Authors: He W.-J., Zhang L., Yi S.Y., Tang X.L., Yuan Q.-S., Guo M.-W., Gong A.-D., Wu A.B., Qu B., Li H.-P., Liao Y.-C.
Keywords: Fusarium; S3-4; AKR18A1; DON; Detoxification
Published: 2/08/2017
Repository: https://www.ncbi.nlm.nih.gov/pmc/articles/PMC5573404/
This research was supported by the Ministry of Science and Technology of China MOST (2016YFE0112900)
CC-BY license http://creativecommons.org/
Brazil produces approximately 40 000 tons of Brazil nuts annually, which is commonly contaminated with fungi and mycotoxins. Gaseous allyl isothiocyanate (AITC) was used to inhibit the growth of Aspergillus parasiticus and its production of aflatoxins (AFs) in Brazil nuts. Gaseous AITC could be used as an alternative to inhibit the growth of A. parasiticus during storage and transport of Brazil nuts. © 2017 Society of Chemical Industry.
Authors: Lopes LF, Bordin K, de Lara GH, Saladino F, Quiles JM, Meca G, Luciano FB.
Repository: 10.1002/jsfa.8527
Keywords: food quality; food safety; mycotoxins; natural products with biocidal activity; shelf life
Published: 12/08/2017
This work has received funding form the the EU’s H2020 research and innovation programme under GA No 678781- MycoKey.
Request to publish this articles under open access model are ongoing. End of switch procedure are foreseen to be on August 2018
The occurrence of fungi and mycotoxins in foods modify sensorial properties and represents a health risk for consumers, and the use of natural antimicrobials may be an alternative to reduce this problem. The objective of this study was evaluate the potential of allyl isothiocyanate (AITC) in inhibit the production of mycotoxins in corn kernels by Aspergillus parasticus, Fusarium tricinctum, Fusarium verticillioides, Alternaria alternata and Gibberela zeae.
Authors: Bruno Ludvig Tracz (1) , Keliani Bordin (1), Tiago de Melo Nazareth(1), Leandro Batista Costa (1), Renata Ernlund Freitas de Macedo (1), Giuseppe Meca (2), Fernando Bittencourt Luciano (1)
Repository: https://zenodo.org/record/1123225
Keywords: Essential oil; Mycotoxigenic fungi; Stored grains; Natural compounds
Published: 12/10/2016
This work has received funding form the the EU’s H2020 research and innovation programme under GA No 678781- MycoKey.
CC-BY license http://creativecommons.org/
This paper shows the high risk due to the contamination of important food crops (cereals, grape and dried fruit) by high genetically different fungal species of Aspergillus genus that produce Ochratoxin A and Fumonisins, which are cancer related metabolites. The studies of the genetics of these Aspergilli are very important for a better prevention in the field.
Authors: Susca Antonia; Proctor Robert H; Morelli Massimiliano; Haidukowski Miriam; Gallo Antonia; Logrieco Antonio F; Moretti Antonio
Keywords: fum cluster, ota cluster, fumonisin, ochratoxin, biosynthetic gene cluster, Aspergillus niger, Aspergillus welwitschiae
Published: 9/9/2016
Repository: https://www.zenodo.org/record/161680
This work has received funding form the the EU’s H2020 research and innovation programme under GA No 678781- MycoKey.
CC-BY license http://creativecommons.org/
The aims of this study were to evaluate the antifungal activity of the bioactive compound allyl isothiocyanate (AITC) against Aspergillus flavus (8111 ISPA) aflatoxins (AFs) producer and Penicillium verrucosum (D-01847 VTT) ochratoxin A (OTA) producer on corn, barley, and wheat. The experiments were carried out initially in a simulated silo system for laboratory scale composed of glass jars (1 L). Barley and wheat were contaminated with P. verrucosum and corn with A. flavus.
Authors: Juan Manuel Quiles , Tiago de Melo Nazareth, Carlos Luz , Fernando Bittencourt Luciano, Jordi Mañes, Giuseppe Meca
Keywords: Aspergillus flavus; Penicillium verrucosum; AITC; fungal growth reduction; mycotoxin reduction
Published: 01/03/2019
Repository: https://zenodo.org/record/2582853#.XH0KQIhKiM8
This work has received funding form the the EU’s H2020 research and innovation programme under GA No 678781- MycoKey.
The study provides insights about the performance profile of rapid methods currently applied for mycotoxin screening. Addressing EU official guidelines, a collaborative exercise was organized to verify the fitness-for-purpose of FPIA, ELISA, LFD, and LC-HRMS screening methods when applied by first time users. Besides method performances, the practicality of the evaluated screening methods is critically discussed herein.
Authors: Veronica M. T. Lattanzio, Christoph von Holst, Vincenzo Lippolis, Annalisa De Girolamo, Antonio F. Logrieco, Hans G. J. Mol, Michelangelo Pascale
Keywords: mycotoxins; screening; validation; immunoassay; mass spectrometry; cereals
Published: 20/02/2019
Repository: https://www.zenodo.org/record/161680
This work has received funding form the the EU’s H2020 research and innovation programme under GA No 678781- MycoKey.
CC-BY license http://creativecommons.org/
The MLST analysis of ITS-TEF1 concatenated datasets reclassified ITEM 908 as T. atrobrunneum, a species recently described within the T. harzianum species complex and phylogenetically close to T. afroharzianum and T. guizhouense. Genomic analysis revealed the presence of a broad range of genes encoding for carbohydrate active enzymes (CAZYmes), proteins involved in secondary metabolites production, peptaboils, epidithiodioxopiperazines and siderophores potentially involved in parasitism, saprophytic degradation as well as in biocontrol and antagonistic activities. This abundance is comparable to other Trichoderma spp. in the T. harzianum species complex, but broader than in other biocontrol species and in the species T. reesei, known for its industrial application in cellulase production. Comparative analysis also demonstrated similar genomic organization of major secondary metabolites clusters, as in other Trichoderma species.
Authors: Francesca Fanelli; Vania Cosma Liuzzi; Antonio Francesco Logrieco; Claudio Altomare
Keywords: Antagonism; Biocontrol; CAZYmes; Comparative genomics; Mycoparasitism; Peptaibols; Secondary metabolites; Trichoderma
Published: 11/9/2018
Repository: https://www.ncbi.nlm.nih.gov/pubmed/30200883
This work has received funding form the the EU’s H2020 research and innovation programme under GA No 678781- MycoKey.
CC-BY license http://creativecommons.org/
The presence of mycotoxins in herbal medicines is an established problem throughout the entire world. The sensitive and accurate analysis of mycotoxin in complicated matrices (e.g., herbs) typically involves challenging sample pretreatment procedures and an efficient detection instrument. However, although numerous reviews have been published regarding the occurrence of mycotoxins in herbal medicines, few of them provided a detailed summary of related analytical methods for mycotoxin determination. This review focuses on analytical techniques including sampling, extraction, cleanup, and detection for mycotoxin determination in herbal medicines established within the past ten years. Dedicated sections of this article address the significant developments in sample preparation, and highlight the importance of this procedure in the analytical technology. This review also summarizes conventional chromatographic techniques for mycotoxin qualification or quantitation, as well as recent studies regarding the development and application of screening assays such as enzyme-linked immunosorbent assays, lateral flow immunoassays, aptamer-based lateral flow assays, and cytometric bead arrays. The present work provides a good insight regarding the advanced research that has been done and closes with an indication of future demand for the emerging technologies.
Authors: Lei Zhang , Xiao-Wen Dou 1 Cheng Zhang , Antonio F. Logrieco , Mei-Hua Yang
Keywords: chromatographic methods; herbal medicines; mycotoxin; rapid detection method; sample pretreatment; sampling
Published: 02/02/2018
Repository: https://www.ncbi.nlm.nih.gov/pubmed/29393905
This work was supported by the National Key R&D Program of China (2016YFE0112900), EU project H2020-E.U.3.2-678781-MycoKey, CAMS Innovation Fund for Medical Sciences (CIFMS, 2016-I2M-1-012, 2017-I2M-1-013), and National Project for Standardization of Chinese Materia Medica (ZYBZH-Y-JIN-34). CC-BY license http://creativecommons.org/
MycoKey, an EU-funded Horizon 2020 project, includes a series of “Roundtable Discussions” to gather information on trending research areas in the field of mycotoxicology. This paper includes summaries of the Roundtable Discussions on Chemical Detection and Monitoring of mycotoxins and on the role of genetics and biodiversity in mycotoxin production. Discussions were managed by using the nominal group discussion technique, which generates numerous ideas and provides a ranking for those identified as the most important. Four questions were posed for each research area, as well as two questions that were common to both discussions. Test kits, usually antibody based, were one major focus of the discussions at the Chemical Detection and Monitoring roundtable because of their many favorable features, e.g., cost, speed and ease of use. The second area of focus for this roundtable was multi-mycotoxin detection protocols and the challenges still to be met to enable these protocols to become methods of choice for regulated mycotoxins. For the genetic and biodiversity group, both the depth and the breadth of trending research areas were notable. For some areas, e.g., microbiome studies, the suggested research questions were primarily of a descriptive nature. In other areas, multiple experimental approaches, e.g., transcriptomics, proteomics, RNAi and gene deletions, are needed to understand the regulation of toxin production and mechanisms underlying successful biological controls. Answers to the research questions will provide starting points for developing acceptable prevention and remediation processes. Forging a partnership between scientists and appropriately-placed communications experts was recognized by both groups as an essential step to communicating risks, while retaining overall confidence in the safety of the food supply and the integrity of the food production chain.
Authors: John F. Leslie , Veronica Lattanzio , Kris Audenaert , Paola Battilani , Jeffrey Cary , Sofia N. Chulze , Sarah De Saeger , Annamaria Gerardino , Petr Karlovsky , Yu-Cai Liao , Chris M. Maragos , Giuseppe Meca , Angel Medina , Antonio Moretti , Gary Munkvold , Giuseppina Mulè , Patrick Njobeh , Ivan Pecorelli , Giancarlo Perrone , Amedeo Pietri , Juan M. Palazzini , Robert H. Proctor , Endang S. Rahayu , Maria L. Ramírez , Robert Samson , Jörg Stroka , Michael Sulyok , Mark Sumarah , Cees Waalwijk , Qi Zhang , Hao Zhang ,Antonio F. Logrieco
Keywords: antibodies; biological control; communication with non-scientists; metabolomics; microbiome; multi-mycotoxin detection protocols; nominal group discussion technique; proteomics; transcriptomics
Published: 01/03/2018
Repository: https://www.ncbi.nlm.nih.gov/pubmed/29494529
This work has received funding form the the EU’s H2020 research and innovation programme under GA No 678781- MycoKey and the Kansas Agricultural Experiment Station and the Feed the Future Innovation Lab for the Reduction of Postharvest Losses.
CC-BY license http://creativecommons.org/
Fusarium head blight (FHB) is a devastating disease that causes extensive yield and quality losses to wheat and other small cereal grains worldwide. Species within the Fusarium graminearum complex are the main pathogens associated with the disease, F. graminearum sensu stricto being the main pathogen in Argentina. Biocontrol can be used as part of an integrated pest management strategy. Phytohormones play a key role in the plant defense system and their production can be induced by antagonistic microorganisms. The aims of this study were to evaluate the effect of the inoculation of Bacillus velezensis RC 218, F. graminearum and their co-inoculation on the production of salicylic acid (SA) and jasmonic acid (JA) in wheat spikes at different periods of time under greenhouse conditions, and to evaluate the effect of B. velezensis RC 218 and Streptomyces albidoflavus RC 87B on FHB disease incidence, severity and deoxynivalenol accumulation on Triticum turgidum L. var. durum under field conditions. Under greenhouse conditions the production of JA was induced after F. graminearum inoculation at 48 and 72 h, but JA levels were reduced in the co-inoculated treatments. No differences in JA or SA levels were observed between the B. velezensis treatment and the water control. In the spikes inoculated with F. graminearum, SA production was induced early (12 h), as it was shown for initial FHB basal resistance, while JA was induced at a later stage (48 h), revealing different defense strategies at different stages of infection by the hemibiotrophic pathogen F. graminearum. Both B. velezensis RC 218 and S. albidoflavus RC 87B effectively reduced FHB incidence (up to 30%), severity (up to 25%) and deoxynivalenol accumulation (up to 51%) on durum wheat under field conditions.
Authors: Juan Palazzini , Pablo Roncallo , Renata Cantoro , María Chiotta , Nadia Yerkovich , Sofía Palacios , Viviana Echenique , Adriana Torres , María Ramirez , Petr Karlovsky, Sofía Chulze ,
Repository: https://www.ncbi.nlm.nih.gov/pmc/articles/PMC5848189/
Keywords: biocontrol; durum wheat; phytohormones; wheat defense modulation
Published: 20/02/2018
This work has received funding form the the EU’s H2020 research and innovation programme under GA No 678781- MycoKey.
CC-BY license http://creativecommons.org/
Aflatoxin B1 (AFB1) is a very hazardous carcinogen, readily contaminating foodstuffs and traditional Chinese medicines (TCMs) that has inspired increasing health concerns due to dietary exposure. Colloidal nanocrystals have been proposed as optical labels for aptasensor assembly, but these typically require tedious multistep conjugation and suffer from unsatisfactory robustness when used for complex matrices. In the present study, we report a rapid and sensitive method for screening for trace AFB1 levels in TCMs using a label-free fluorescent aptasensor PicoGreen dye-based strategy. Using PicoGreen to selectively measure complementary double-stranded DNA, fluorescence enhancement due to dsDNA is ‘turned off’ in the presence of AFB1 due binding of aptamer target over complementary sequence. Self-assembly of a label-free fluorescent aptasensor based on AFB1 aptamer and PicoGreen dye was performed. Due to competition between the complementary sequence and AFB1 target, this rapid method was capable of highly sensitive and selective screening for AFB1 in five types of TCMs. This proposed approach had a limit of detection as low as 0.1 μg·L−1 and good linearity with a range of 0.1–10 μg·L−1 (0.1–10 ppb). Among the 20 samples tested, 6 batches were found to be contaminated with AFB1 using this method, which was confirmed using sophisticated liquid chromatography-electrospray ionization-tandem mass spectrometry/mass spectrometry analysis. The results of this study indicate the developed method has the potential to be a simple, quick, and sensitive tool for detecting AFB1 in TCMs.
Authors: Cheng Zhang , Xiaowen Dou , Lei Zhang , Meifeng Sun , Ming Zhao , Zhen OuYang, Dandan Kong , F. Logrieco Antonio, Meihua Yang
Keywords: aflatoxin B1, aptamer, PicoGreen, fluorescence, traditional Chinese medicines
Published: 28/02/2018
Repository: https://www.ncbi.nlm.nih.gov/pmc/articles/PMC5869389/
This work was supported by National Key R&D Program of China (2016YFE0112900), EU project H2020-E.U.3.2-678781-MycoKey, National Project for Standardization of Chinese Materia Medica (ZYBZH-Y-JIN-34), CAMS Innovation Fund for Medical Sciences (2016-I2M-1-012, 2017-I2M-1-013). CC-BY license http://creativecommons.org/
Post-translational modifications of chromatin structure by histone acetyltransferase (HATs) play a central role in the regulation of gene expression and various biological processes in eukaryotes. Although HAT genes have been studied in many fungi, few of them have been functionally characterized. In this study, we identified and characterized four putative HATs (FgGCN5, FgRTT109, FgSAS2, FgSAS3) in the plant pathogenic ascomycete Fusarium graminearum, the causal agent of Fusarium head blight of wheat and barley. We replaced the genes and all mutant strains showed reduced growth of F. graminearum. The ΔFgSAS3 and ΔFgGCN5 mutant increased sensitivity to oxidative and osmotic stresses. Additionally, ΔFgSAS3 showed reduced conidia sporulation and perithecium formation. Mutant ΔFgGCN5 was unable to generate any conidia and lost its ability to form perithecia. Our data showed also that FgSAS3 and FgGCN5 are pathogenicity factors required for infecting wheat heads as well as tomato fruits. Importantly, almost no Deoxynivalenol (DON) was produced either in ΔFgSAS3 or ΔFgGCN5 mutants, which was consistent with a significant downregulation of TRI genes expression. Furthermore, we discovered for the first time that FgSAS3 is indispensable for the acetylation of histone site H3K4, while FgGCN5 is essential for the acetylation of H3K9, H3K18, and H3K27. H3K14 can be completely acetylated when FgSAS3 and FgGCN5 were both present. The RNA-seq analyses of the two mutant strains provide insight into their functions in development and metabolism. Results from this study clarify the functional divergence of HATs in F. graminearum, and may provide novel targeted strategies to control secondary metabolite expression and infections of F. graminearum.
Authors: Xiangjiu Kong, Anne D. van Diepeningen, Theo A. J. van der Lee, Cees Waalwijk, Jingsheng Xu1, Jin Xu1, Hao Zhang1, Wanquan Chen1, Jie Feng1
Keywords: Fusarium graminearum; deoxynivalenol; histone acetyltransferase; pathogenicity; secondary metabolism
Published: 26/04/2018
Repository: https://www.ncbi.nlm.nih.gov/pubmed/29755419
This work has received funding from the National Key R&D Program of China (2016YFE0112900, 2016YFD0300705) and European Union’s Horizon 2020 research and innovation programme under grant agreement No 678781 (MycoKey) and Fundamental Research Funds for Central Non-profit Scientific Institution (Y2017XM01).CC-BY license http://creativecommons.org/
In this study, we carried out a genome-wide analysis of family-1 UDP glycosyltransferases in wheat based on the PSPG conserved box that resulted in the identification of 179 putative UGT genes. The identified genes were clustered into 16 major phylogenetic groups with a lack of phylogenetic group K. The UGTgenes were invariably distributed among all the chromosomes of the 3 genomes. At least 10 intron insertion events were found in the UGT sequences, where intron 4 was observed as the most conserved intron. The expression analysis of the wheat UGT genes using both online microarray data and quantitative real-time PCR verification suggested the distinct role of UGT genes in different tissues and developmental stages. The expression of many UGT genes was up-regulated after Fusarium graminearum inoculation, and six of the genes were further verified by RT-qPCR.
Authors: Yi He, Dawood Ahmad, Xu Zhang, Yu Zhang, Lei Wu, Peng Jiang and Hongxiang Ma
Keywords: Deoxynivalenol; Expression pattern; Fusarium head blight; Phylogeny; UDP-glycosyltransferase; Wheat
Published: 19/04/2018
Repository: https://www.ncbi.nlm.nih.gov/pmc/articles/PMC5923315/
This work was partially supported by the National Key Project for the Research and Development of China (2016YFE0112900, 2016YFD0100500), China Agricultural Research System Program (CARS-03), National Natural Science Foundation of China (31561143004), Natural Science Foundation of Jiangsu province, China (BK20170605) and European Union Horizon 2020 Mycokey project (EU678781).
CC-BY license http://creativecommons.org/
In recent years, Fusarium head blight (FHB) outbreaks have occurred much more frequently in China. The reduction of burning of the preceding crop residues is suggested to contribute to more severe epidemics as it may increase the initial inoculum. In this study, a large number of Fusarium isolates was collected from blighted wheat spikes as well as from rice stubble with perithecia originating from nine sampling sites in five provinces in Southern China. Fusarium asiaticum dominated both wheat and rice populations, although rice populations showed a higher species diversity. Chemotype analysis showed that rice is the preferred niche for NIV mycotoxin producers that were shown to be less virulent on wheat. In contrast, 3ADON producers are more prevalent on wheat and in wheat producing areas. The 3ADON producers were shown to be more virulent on wheat, revealing the selection pressure of wheat on 3ADON producers. For the first time, members of the Incarnatum-clade of Fusarium Incarnatum–Equiseti Species Complex (FIESC) were found to reproduce sexually on rice stubble. The pathogenicity of FIESC isolates on wheat proved very low and this may cause the apparent absence of this species in the main wheat producing provinces. This is the first report of the Fusarium population structure including rice stubble as well as a direct comparison with the population on wheat heads in the same fields. Our results confirm that the perithecia on rice stubble are the primary inoculum of FHB on wheat and that cropping systems affect the local Fusarium population.
Authors: Meixin Yang 1,†, Hao Zhang 1,†, Xiangjiu Kong 1, Theo van der Lee 2, Cees Waalwijk , Anne van Diepeningen 2, Jin Xu 1, Jingsheng Xu 1, Wanquan Chen 1,* and Jie Feng 1,*
Keywords: Fusarium head blight; chemotype; cropping system; rice stubble
Published: 08/03/2018
Repository: https://www.ncbi.nlm.nih.gov/pmc/articles/PMC5923315/
This work received funding from the National Key R&D Program of China (2016YFE0112900, 2016YFD0300705) and the European Union’s Horizon 2020 research and innovation programme
under grant agreement No. 678781 (MycoKey) and the National Natural Science Foundation of China (No. 31201477) and Fundamental Research Funds for Central Non-Profit Scientific Institution (Y2017XM01).
CC-BY license http://creativecommons.org/
Mycotoxins are major food contaminants affecting global food security, especially in low and middle-income countries. The European Union (EU) funded project, MycoKey, focuses on “Integrated and innovative key actions for mycotoxin management in the food and feed chains” and the right to safe food through mycotoxin management strategies and regulation, which are fundamental to minimizing the unequal access to safe and sufficient food worldwide. As part of the MycoKey project, a Mycotoxin Charter (charter.mycokey.eu) was launched to share the need for global harmonization of mycotoxin legislation and policies and to minimize human and animal exposure worldwide, with particular attention to less developed countries that lack effective legislation. This document is in response to a demand that has built through previous European Framework Projects—MycoGlobe and MycoRed—in the previous decade to control and reduce mycotoxin contamination worldwide. All suppliers, participants and beneficiaries of the food supply chain, for example, farmers, consumers, stakeholders, researchers, members of civil society and government and so forth, are invited to sign this charter and to support this initiative.
Authors: Antonio F. Logrieco ; J. David Miller; Mari Eskola; Rudolf Krska, Amare Ayalew; Ranajit Bandyopadhyay; Paola Battilani; Deepak Bhatnagar; Sofia Chulze; Sarah De Saeger; Peiwu Li; Giancarlo Perrone; Amnart Poapolathep; Endang S. Rahayu; Gordon S. Shephard; François Stepman; Hao Zhang; John F. Leslie.
Keywords: United Nations Sustainable Development Goals; consumers; education and outreach; food production; food safety; food security; health risks; trade
Published: 04/04/2018
Repository: https://www.ncbi.nlm.nih.gov/pmc/articles/PMC5923315/
This work has received funding form the the EU’s H2020 research and innovation programme under GA No 678781- MycoKey.
CC-BY license http://creativecommons.org/
The aim of this work was to evaluate the capability of a laccase (LC) from Pleurotus eryngii and a laccase-mediator systems (LMSs) to degrade aflatoxin B1 (AFB1), fumonisin B1 (FB1), ochratoxin A (OTA), deoxynivalenol (DON), Zearalenone (ZEN) and T-2 toxin in in vitro assays. In addition, the simultaneous mycotoxin degradation capability with selected LMSs was evaluated with combinations of AFB1 and ZEN, and FB1 and T-2 toxin.
Authors: Martina Loi; Francesca Fanelli; Maria Teresa Cimmarusti; Valentina Mirabelli Miriam Haidukowski; Antonio F.Logrieco; Rocco Caliandro; Giuseppina Mule
Repository: https://zenodo.org/record/1216974
Keywords: Mycotoxins; Bioremediation; Laccase-Mediator System; Multi-mycotoxin degradation
Published: 14/03/2018
This work has received funding form the the EU’s H2020 research and innovation programme under GA No 678781- MycoKey.
CC-BY license http://creativecommons.org/
Food spoilage caused by mycotoxigenic moulds represents an important problem in food security. The antimicrobial peptides are compounds of natural origin constituted by a variable number (5–100) of amino acids held together through peptide bonds. In this work, the cell free supernatants (CFSs) containing peptides obtained from four strains of LAB were lyophilized, filtered and tested to determine the antifungal activity against Aspergillus Parasiticus and Penicillium expansum. CFS obtained by Lactobacillus plantarum showed the highest inhibition activity. CFS was fractionated by size exclusion chromatography and injected into the liquid chromatography coupled to diode array detector. One of the recollected fractions resulted interesting for the presence of three peaks that were purified by the technique of the LC-DAD using a semi preparative C18 column.
Authors: C.Luz; F.Saladino; F.B.Luciano; J.Mañes; G.Meca
Keywords: Antimicrobial peptides; Antifungal activity; Lactobacillus plantarum; Spoilage fungi
Published: 31/03/2017
Repository: https://zenodo.org/record/1167602
This work has received funding form the the EU’s H2020 research and innovation programme under GA No 678781- MycoKey.
CC-BY license http://creativecommons.org/
Aflatoxin M1 removal and potential applications of a laccase enzyme from Pleurotus eryngii for milk safety – Aflatoxin M1 (AFM1), is the main catabolite deriving from the hydroxylation of aflatoxin B1 (AFB1), found in the milk of animals fed with AFB1 contaminated feeds. The International Agency for the Research on Cancer (IARC) has classified it in group 2B, thus possibly carcinogenic for humans. Their maximum limit in raw milk, heat-treated milk and milk for the manufacture of milk-based products, has been set by the Regulation (EC) 1881 of 2006 to 50ng/kg. AFM1 resists to the most common treatments of food industry and persists in processed product. Its occurrence has been registered throughout the whole dairy supply chain, including yogurts and cheeses, and it represents a serious risk for humans and animals. The development of mild, green and efficient methods for AFM1 degradation is an actual and crucial topic.
Authors: Martina Loi, Laura Quintieri, Francesca Fanelli, Vania C. Liuzzi, Miriam Haidukowski, Antonio F. Logrieco, Giuseppina Mulè
Keywords:safety, milk, laccase, aflatoxin M1, protein cross-linking, milk texture, allergenicity
Published: 10/05/2016
Repository: https://zenodo.org/record/822778
This work has received funding form the the EU’s H2020 research and innovation programme under GA No 678781- MycoKey.
CC-BY license http://creativecommons.org/
This paper shows the high risk due to the contamination of important food crops (cereals, grape and dried fruit) by high genetically different fungal species of Aspergillus genus that produce Ochratoxin A and Fumonisins, which are cancer related metabolites. The studies of the genetics of these Aspergilli are very important for a better prevention in the field.
Authors: Susca Antonia; Proctor Robert H; Morelli Massimiliano; Haidukowski Miriam; Gallo Antonia; Logrieco Antonio F; Moretti Antonio
Keywords: fum cluster, ota cluster, fumonisin, ochratoxin, biosynthetic gene cluster, Aspergillus niger, Aspergillus welwitschiae
Published: 9/9/2016
Repository: https://www.zenodo.org/record/161680
This work has received funding form the the EU’s H2020 research and innovation programme under GA No 678781- MycoKey.
CC-BY license http://creativecommons.org/